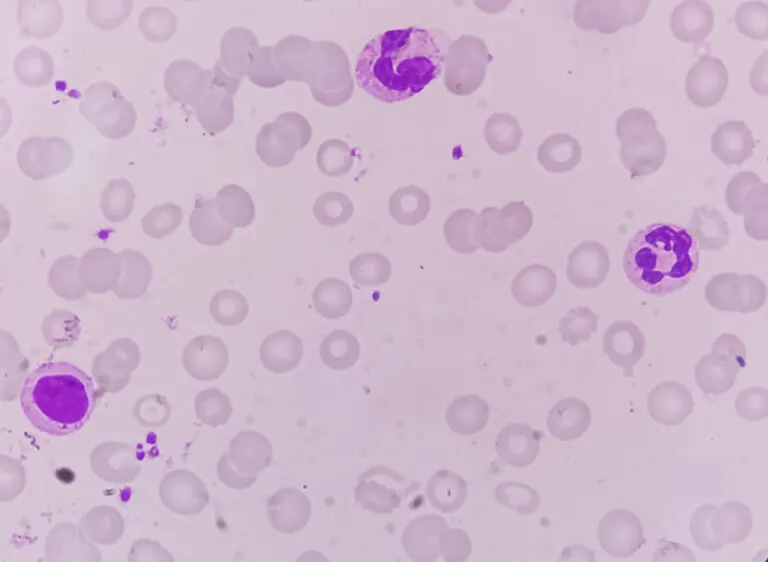

High or Low RDW in Blood Count: What Does It Mean?


Reviewed and approved by the doctor Leonardo Biolatto
One of the parameters that often cause concern after receiving the results of a blood count is the RDW (red cell blood distribution width) or ‘red cell distribution width test’. It indicates the variability in the size of red blood cells, which are responsible for transporting oxygen from the lungs to the rest of the body’s cells. What do high or low values indicate?
A high RDW indicates that there’s a significant difference between the size of the smallest and largest red blood cells. It usually applies to those situations where many red blood cells are larger than normal, although the opposite can also be true. This criterion is regularly used in the diagnosis of anemia.
If the values are below what is considered normal, it doesn’t usually indicate a disease, unless it’s observed that other variables – such as mean corpuscular volume (MCV)- are also low. In the following article, we’re going to tell you more about the significance of this indicator in the CBC.
We think you may also enjoy reading this article: A New Blood Test that Detects Tumors Before Symptoms Occur
What is RDW?
The RDW (red blood cell distribution width) is a parameter that is part of the complete blood count or CBC test. It reflects the size distribution of red blood cells (erythrocytes) and is expressed in percentages, with normal values being 12 to 15%.
A term that usually refers to something similar is anisocytosis, although the latter is a consequence of direct observation of red blood cells in a peripheral blood smear (under the microscope).
We think you may also enjoy reading this article: Stress and High Blood Pressure: How Are They Related?
Returning to RDW, if the percentage is higher than 15%, it’s indicative of alterations in the blood. It’s not a very specific parameter, as the causes of these volume variations can be very diverse, such as vitamin B12 deficiency and alcoholism.
Therefore, it’s a test that is traditionally used to diagnose the different types of anemia. Sometimes it’s also used simultaneously with other tests to confirm conditions such as thalassemia, liver and kidney disease, diabetes, and even some types of hematological tumors.
What does a high RDW value on a CBC mean?
When the RDW is high on the CBC it means that there is a greater variation in the size of the red blood cells. When RDW values are observed to be high, an interpretation is made along with hemoglobin and mean corpuscular volume (MCV) levels to distinguish between different types of anemia or other diseases.
Its most common causes include the following conditions:
- Iron deficiency anemia: This occurs because of iron deficiency, so hemoglobin cannot be synthesized properly. Therefore, hemoglobin would be low and MCV decreased.
- Megaloblastic anemia: This is caused by a deficiency of folic acid or vitamin B12, necessary for DNA synthesis in the precursors of these cells. Hemoglobin would be low and MCV high, typical of this disease.
- Thalassemias: These are a group of genetic disorders in which abnormal forms of hemoglobin are synthesized. Both hemoglobin and MCV would be low.
- Liver disease: Since the livers functions of metabolism and elimination of waste substances are impaired when there’s a disease present, the size of red blood cells is often altered.
The results of research published in the journal Plos One suggest that high RDW in the blood count has a predictive value for other chronic diseases, such as type 2 diabetes, cardiovascular pathologies (especially heart failure), and cancer.
At present, there’s no specific treatment to restore RDW values to normal levels. That’s why it’s necessary to obtain a diagnosis of the disease that is causing the alteration in order to follow an adequate and effective protocol.
Recommendations for lowering a high RDW
To lower a high RDW, it’s necessary to intervene on the underlying cause. Treatment options vary depending on the related disease. However, some general advice to help restore these parameters to normal values is as follows:
- Get regular physical exercise.
- Sleep between 7 and 9 hours a day.
- Avoid alcohol and tobacco consumption.
- Increase your consumption of foods rich in iron, vitamin B9, or vitamin B12 (depending on the type of anemia).
We think you may be interested in reading this, too: Oncological Blood Tests: What Are They and When Are They Done?
What does a low RDW value mean?
A low RDW count in the CBC is usually of no clinical significance, as it isn’t indicative of a disease. Especially when the other parameters (hemoglobin and MCV) are not altered.
However, if the mean corpuscular volume (MCV) is altered and the RDW is low, it’s necessary to investigate whether this is due to diseases such as kidney problems, HIV, cancer, diabetes, or liver disease. Your doctor may suggest additional tests.
High RDW often indicates anemia
Several disorders that affect red cell volume can lead to an elevated RDW. In most cases, it’s related to deficiency anemias (such as iron deficiency anemia and megaloblastic anemia). It can also indicate thalassemia, liver disease, and other chronic conditions.
Whatever the case, it’s essential to seek medical attention to find out which disease is behind this alteration in the hemogram. Once established, the physician can provide guidance on the appropriate treatment for the situation.
All cited sources were thoroughly reviewed by our team to ensure their quality, reliability, currency, and validity. The bibliography of this article was considered reliable and of academic or scientific accuracy.
-
Fava, C., Cattazzo, F., Hu, Z. D., Lippi, G., & Montagnana, M. (2019). The role of red blood cell distribution width (RDW) in cardiovascular risk assessment: useful or hype? Annals of Translational Medicine, 7(20), 581. https://www.ncbi.nlm.nih.gov/pmc/articles/PMC6861793/
-
Hu, Z., Sun, Y., Wang, Q., Han, Z., Huang, Y., Liu, X., Ding, C., Hu, C., Qin, Q., & Deng, A. (2013). Red blood cell distribution width is a potential prognostic index for liver disease. Clinical Chemistry and Laboratory Medicine, 51(7), 1403–1408. https://pubmed.ncbi.nlm.nih.gov/23314558/
- Loprinzi, P. D. (2015). Sleep duration and sleep disorder with red blood cell distribution width. American Journal of Health Behavior, 39(4), 471–474. https://doi.org/10.5993/AJHB.39.4.3
- Loprinzi, P. D., Loenneke, J. P., & Abe, T. (2015). The association between muscle strengthening activities and red blood cell distribution width among a national sample of U.S. adults. Preventive Medicine, 73(1), 130–132. https://doi.org/10.1016/j.ypmed.2015.01.011
- Said, A. S., Spinella, P. C., Hartman, M. E., Steffen, K. M., Jackups, R., Holubkov, R., Wallendorf, M., & Doctor, A. (2017). RBC Distribution Width: Biomarker for Red Cell Dysfunction and Critical Illness Outcome? Pediatric Critical Care Medicine: a journal of the Society of Critical Care Medicine and the World Federation of Pediatric Intensive and Critical Care Societies, 18(2), 134–142. https://www.ncbi.nlm.nih.gov/pmc/articles/PMC5291765/
- Sharma, D. (2015). Significance of red cell distribution width in the diagnosis of iron deficiency anemia: An observational study from India. Journal of Pediatrics & Neonatal Care, 3(1), 62–65. https://doi.org/10.15406/jpnc.2015.02.00102
This text is provided for informational purposes only and does not replace consultation with a professional. If in doubt, consult your specialist.







